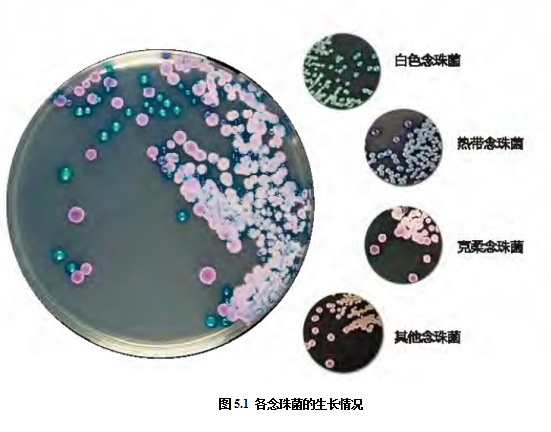
1.png
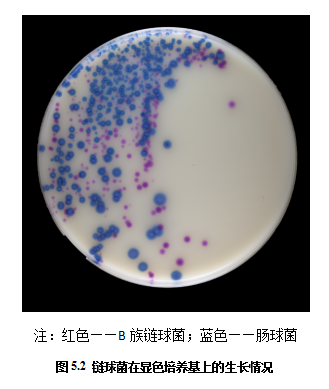
2.png
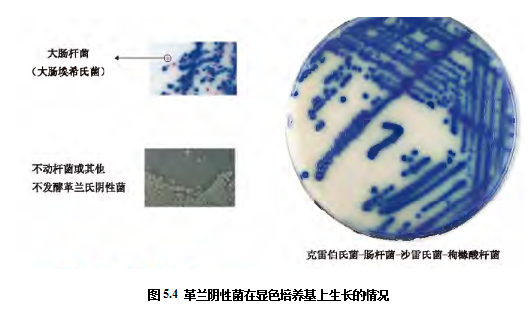
4.png
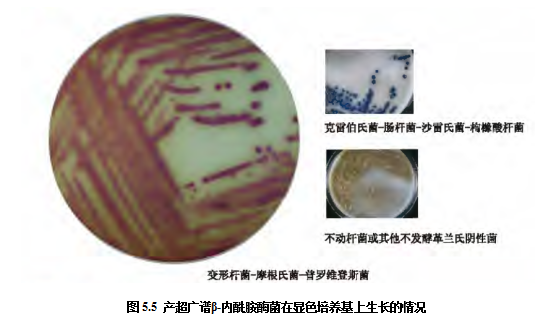
5.png
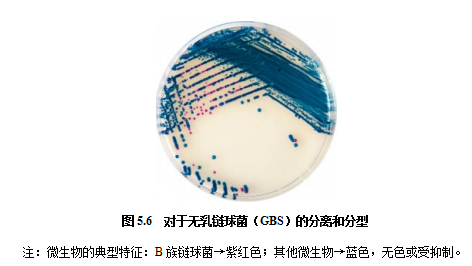
6.png
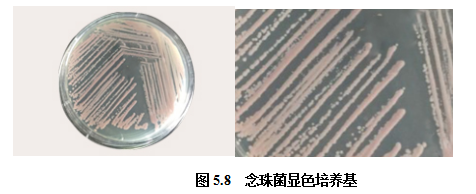
8.png
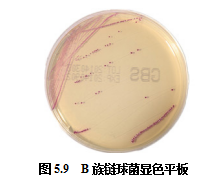
9.png

第一節(jié) 引言
一、微生物檢測(cè)的發(fā)展現(xiàn)狀
目前,微生物實(shí)驗(yàn)室使用的檢測(cè)產(chǎn)品,大部分依然以傳統(tǒng)方法為基礎(chǔ),首先對(duì)標(biāo)本進(jìn)行預(yù)處理,根據(jù)涂片染色的結(jié)果,選擇合適的培養(yǎng)基進(jìn)行分離培養(yǎng);根據(jù)菌落特點(diǎn),選擇適當(dāng)?shù)纳磻?yīng)或者上自動(dòng)化儀器進(jìn)行鑒定;藥敏檢測(cè)則采用紙片法、液體增菌培養(yǎng)法或者直接上自動(dòng)化儀器進(jìn)行表型藥敏檢測(cè)。無論是國(guó)內(nèi)還是國(guó)際,微生物的檢測(cè)一直是手工法、半自動(dòng)化、全自動(dòng)化共存,以基礎(chǔ)微生物方法為主,結(jié)合形態(tài)學(xué)、免疫和分子生物學(xué)等輔助手段。
往年認(rèn)為細(xì)菌檢測(cè),也就是檢測(cè)細(xì)菌生長(zhǎng)分裂的過程,在技術(shù)上無法用自動(dòng)化儀器取代,尤其是標(biāo)本處理和培養(yǎng)。2016年國(guó)內(nèi)在這方面得到了突破,我國(guó)研制出了標(biāo)本處理和培養(yǎng)自動(dòng)化的機(jī)器人,如百博生物的微生物樣本處理智能機(jī)器人ET-2000。自動(dòng)化儀器逐漸貫穿整個(gè)臨床微生物檢測(cè)(標(biāo)本的前處理→微生物培養(yǎng)→鑒定→數(shù)據(jù)的管理)的全過程,國(guó)外多年前已經(jīng)實(shí)現(xiàn)此半自動(dòng)或全自動(dòng)過程,但是我國(guó)仍處在努力研制的過程中。另外,隨著基因診斷技術(shù)的發(fā)展,微生物檢測(cè)不再需要增菌培養(yǎng),直接對(duì)標(biāo)本進(jìn)行檢測(cè)的產(chǎn)品逐漸發(fā)展起來,尤其是免疫技術(shù)和分子生物學(xué)技術(shù)的應(yīng)用,為微生物檢測(cè)提供了很多輔助手段。由于方法學(xué)的局限性,臨床對(duì)于微生物檢測(cè)產(chǎn)品的提升需求,主要集中在提高檢測(cè)速度、減少人工操作、加強(qiáng)準(zhǔn)確性等方面。另外,對(duì)于藥敏檢測(cè)的結(jié)果解釋、院感控制和耐藥分析也提出了越來越高的要求。
第二節(jié) 微生物檢測(cè)相關(guān)政策法規(guī)及國(guó)標(biāo)行標(biāo)的變化
一、微生物檢測(cè)相關(guān)政策法規(guī)的變化
總局在2016年2月發(fā)布了進(jìn)一步加強(qiáng)了醫(yī)療器械的監(jiān)督抽驗(yàn)工作的通知,全國(guó)各省市響應(yīng)總局要求,紛紛出臺(tái)相關(guān)政策,加強(qiáng)醫(yī)療器械產(chǎn)品的市場(chǎng)監(jiān)督抽查,涉及微生物檢測(cè)產(chǎn)品、免疫檢測(cè)產(chǎn)品、無菌器械、有源器械等近百種產(chǎn)品的各種飛行檢查、市場(chǎng)監(jiān)督抽查層出不窮。2016年醫(yī)療器械行業(yè)的日常監(jiān)督抽驗(yàn)及飛行檢查頻率比往年強(qiáng)度加大,從而也一定程度上規(guī)范了生產(chǎn)及經(jīng)營(yíng)企業(yè)的內(nèi)部質(zhì)量體系管理和外部經(jīng)營(yíng)管理,但是也存在過度監(jiān)管的可能,同時(shí)導(dǎo)致企業(yè)的管理成本也比往年成倍數(shù)增長(zhǎng)。
2016年4月7日中國(guó)食品藥品監(jiān)督管理局開始實(shí)施《醫(yī)療器械臨床試驗(yàn)質(zhì)量管理規(guī)范》,該規(guī)范指出按照“四個(gè)最嚴(yán)”和“四有兩責(zé)”要求,采取有效措施,加強(qiáng)監(jiān)督檢查,督促本行政區(qū)域內(nèi)醫(yī)療器械臨床試驗(yàn)申辦者和臨床試驗(yàn)機(jī)構(gòu)切實(shí)把《規(guī)范》的要求落實(shí)到臨床試驗(yàn)管理的各個(gè)環(huán)節(jié),保證臨床試驗(yàn)過程科學(xué)規(guī)范,結(jié)果真實(shí)可靠,受試者合法權(quán)益得到充分保障。因此,該規(guī)范的實(shí)施導(dǎo)致生產(chǎn)企業(yè)新產(chǎn)品注冊(cè)過程中尋找臨床實(shí)驗(yàn)單位的難度增大。一方面原因是臨床單位原屬于衛(wèi)生部及衛(wèi)生系統(tǒng)監(jiān)督和管理,對(duì)藥監(jiān)系統(tǒng)的相關(guān)法律法規(guī)不熟悉,目前來說很難按照藥監(jiān)系統(tǒng)的相關(guān)法律法規(guī)進(jìn)行規(guī)范化操作;另一方面,中國(guó)的國(guó)情決定了目前解決不了的醫(yī)務(wù)人員不足的困難,醫(yī)務(wù)人員工作量龐大,同時(shí)涉及到個(gè)人的業(yè)務(wù)和績(jī)效,臨床單位不愿意承擔(dān)臨床試驗(yàn)帶來的風(fēng)險(xiǎn),加大了臨床試驗(yàn)的難度。
2016年09月22日總局關(guān)于發(fā)布醫(yī)療器械冷鏈(運(yùn)輸、貯存)管理指南的公告(2016年第154號(hào)),對(duì)微生物檢測(cè)產(chǎn)品的生產(chǎn)、銷售和經(jīng)營(yíng)無疑是一個(gè)沉重的打擊。微生物檢測(cè)產(chǎn)品,主要以培養(yǎng)基為主,具有貨值低廉、占用空間大、利潤(rùn)低的特點(diǎn),并且其儲(chǔ)存條件大部分需要2-8℃冷藏或-10℃以下冷凍保存。冷鏈管理指南的出臺(tái)無疑給予微生物檢測(cè)產(chǎn)品一記重拳,自此原本微生物檢測(cè)產(chǎn)品的生產(chǎn)和經(jīng)營(yíng)所帶來的微薄利潤(rùn)將再無利可圖,微生物檢測(cè)產(chǎn)品的相關(guān)生產(chǎn)及經(jīng)營(yíng)企業(yè)只能開始尋找別的出路,紛紛往免疫、基因診斷、自動(dòng)化設(shè)備等方向發(fā)展。
2016年是我國(guó)體外診斷試劑重大變革的一年,近百種法規(guī)政策的出臺(tái)讓人應(yīng)對(duì)不暇,給行業(yè)的發(fā)展帶來了強(qiáng)大的沖擊,同樣也影響著體外診斷試劑重要分支之一的微生物檢測(cè)。微生物檢測(cè)的發(fā)展逐漸由傳統(tǒng)的手工操作轉(zhuǎn)化為自動(dòng)化,分離鑒定培養(yǎng)基得到進(jìn)一步發(fā)展,同時(shí)也引進(jìn)了簡(jiǎn)單快速檢測(cè)的產(chǎn)品。
二、CLSI藥敏試驗(yàn)執(zhí)行標(biāo)準(zhǔn)的變化
我國(guó)微生物實(shí)驗(yàn)室藥敏試驗(yàn)均遵循美國(guó)臨床與實(shí)驗(yàn)室標(biāo)準(zhǔn)化協(xié)會(huì)(Clinical and Laboratory Standards Institute,CLSI)制定的藥敏試驗(yàn)標(biāo)準(zhǔn)。隨著檢測(cè)手段的改進(jìn)及新藥物的成果研制,CLSI至少每年都會(huì)對(duì)藥敏試驗(yàn)執(zhí)行標(biāo)準(zhǔn)進(jìn)行一次更新。藥敏試驗(yàn)執(zhí)行標(biāo)準(zhǔn)不斷更新的目的是為了能夠更加精確的預(yù)測(cè)抗菌藥物體內(nèi)治療效果,指導(dǎo)抗菌藥物合理應(yīng)用。主要包括概念改變、折點(diǎn)改變、方法改變和藥物適應(yīng)癥及使用方法改變等幾個(gè)方面。
2017年CLSI在微生物檢測(cè)方面的標(biāo)準(zhǔn)的變化主要的是藥敏試驗(yàn)標(biāo)準(zhǔn)的變化:僅僅使用術(shù)語(yǔ)“折點(diǎn)”、不再使用“解釋標(biāo)準(zhǔn)”;繼續(xù)刪除過時(shí)的藥物/重新定位老藥;擴(kuò)充對(duì)流行病學(xué)界值的定義/討論;增加腸桿菌科對(duì)粘菌素、淋病奈瑟菌對(duì)阿奇霉素的流行病學(xué)界值;增加了用于腸桿菌科碳青霉烯檢測(cè)的mCIM新方法;修改了紙片擴(kuò)散法質(zhì)控范圍(例如:銅綠假單胞菌ATCC27853對(duì)頭孢吡肟、大腸埃希菌ATCC25922對(duì)美羅培南的紙片擴(kuò)散法質(zhì)控范圍);修改了大腸埃希菌ATCC27853對(duì)美羅培南和金黃色葡萄球菌ATCC29213對(duì)泰地唑胺的MIC質(zhì)控范圍;增加一些正在研發(fā)中的還沒有用于人的新藥物的質(zhì)控范圍;擴(kuò)充了脆弱擬桿菌的MIC問題排除指南;刪除了摩根菌對(duì)四環(huán)素天然耐藥等。
藥敏試驗(yàn)執(zhí)行標(biāo)準(zhǔn)的更新基于體內(nèi)和體外豐富的藥理和臨床數(shù)據(jù),對(duì)臨床結(jié)果報(bào)告具有強(qiáng)有力的指示和指導(dǎo)作用。
第三節(jié) 顯色培養(yǎng)基
隨著臨床實(shí)驗(yàn)室自動(dòng)化、系統(tǒng)化、精準(zhǔn)化步伐的不斷邁進(jìn),對(duì)微生物檢測(cè)試劑提出了更高的要求,傳統(tǒng)的分離培養(yǎng)逐步被免疫、基因診斷、二代測(cè)序、質(zhì)譜分析等新技術(shù)取代,傳統(tǒng)的分離培養(yǎng)基已不能滿足臨床需求,顯色培養(yǎng)基應(yīng)運(yùn)而生。
一、概述
顯色培養(yǎng)基是用于微生物的分離鑒定的培養(yǎng)基,其原理是在選擇性培養(yǎng)基上加入了適量的帶發(fā)色及熒光基團(tuán)的酶底物,發(fā)色團(tuán)(熒光團(tuán))與特殊可識(shí)別的集團(tuán)相連。目標(biāo)微生物產(chǎn)生一些特殊的可水解發(fā)色及熒光底物的酶,使得發(fā)色和熒光基團(tuán)釋放發(fā)出來,從而使目標(biāo)微生物帶上易于辨別的特殊顏色或發(fā)出熒光。是利用微生物不同種屬代謝所產(chǎn)生酶的差異性,在營(yíng)養(yǎng)基質(zhì)中加入相應(yīng)的特異性顯色酶底物以及特定抑制劑,實(shí)現(xiàn)對(duì)目標(biāo)微生物的分離和準(zhǔn)確鑒定。與傳統(tǒng)培養(yǎng)基相比,顯色培養(yǎng)基可有效縮短培養(yǎng)時(shí)間(僅18~24h就可得到初步檢驗(yàn)結(jié)果);降低假陽(yáng)性率,減少后期鑒定工作量(特異性很高);酶顯色底物顯色反應(yīng)特異性強(qiáng),菌落外觀易于辨認(rèn),降低對(duì)檢測(cè)人員技術(shù)水平要求。法國(guó)研究人員于1974 年首次開發(fā)顯色培養(yǎng)基,并將其應(yīng)用于對(duì)大腸桿菌的臨床檢驗(yàn)中,后期應(yīng)用范圍不斷擴(kuò)展,價(jià)值日益凸顯。有關(guān)報(bào)道認(rèn)為:在微生物檢驗(yàn)中應(yīng)用顯色培養(yǎng)基技術(shù)能夠使目標(biāo)微生物著色后的顏色對(duì)比明顯,可方便檢驗(yàn)人員直接從環(huán)節(jié)標(biāo)本培養(yǎng)物中對(duì)目的菌進(jìn)行檢測(cè),對(duì)多種微生物樣本也有良好的快速檢驗(yàn)效果,目前在臨床樣本微生物種類檢測(cè)中應(yīng)用潛力巨大。近年來,有研究人員在顯色培養(yǎng)基基礎(chǔ)上進(jìn)一步簡(jiǎn)化改進(jìn)為快速檢測(cè)紙片法,在有關(guān)微生物菌落總數(shù)、鏈球菌、金黃色葡萄球菌、霉菌、大腸菌群、酵母菌以及李斯特菌等多種微生物的檢測(cè)實(shí)踐中均具有快速性快速、準(zhǔn)確的優(yōu)勢(shì)。
二、顯色培養(yǎng)基生產(chǎn)企業(yè)的概況
目前國(guó)內(nèi)外對(duì)顯色培養(yǎng)基的研究比較成熟的公司主要有:法國(guó)生物梅里埃公司、意大利Biolife公司、法國(guó)CHROMagar(科瑪嘉)公司、北京陸橋技術(shù)股份有限公司、鄭州安圖生物、溫州康泰生物、青島海博生物、廣東環(huán)凱微生物科技有限公司等。
1、Biolife Italiana 公司 Biolife Italiana公司創(chuàng)立于1968年,是一家專業(yè)生產(chǎn)微生物培養(yǎng)基的企業(yè),產(chǎn)品廣泛使用于臨床、工業(yè)和研究實(shí)驗(yàn)室,已開發(fā)出世界標(biāo)準(zhǔn)的創(chuàng)新型微生物培養(yǎng)基并暢銷全球,其產(chǎn)品包括微生物培養(yǎng)基和輔料,特別是在干粉顯色培養(yǎng)基以及添加劑、微生物鑒定試劑盒等生產(chǎn)制造方面有良好的聲譽(yù)。該公司是一家生產(chǎn)高品質(zhì)培養(yǎng)基的企業(yè),是生產(chǎn)臨床與食品微生物顯色培養(yǎng)基的先驅(qū)者,可提供干粉培養(yǎng)基、培養(yǎng)基原料以及添加劑等集成整合服務(wù),尤其在顯色培養(yǎng)基方面有顯著的優(yōu)勢(shì)。產(chǎn)品諸如念珠菌顯色培養(yǎng)基(圖5.1)、B族鏈球菌顯色培養(yǎng)基(圖5.2)、尿道菌顯色培養(yǎng)基(圖5.3)、抗碳青霉烯革蘭陰性菌顯色培養(yǎng)基(圖5.4)、產(chǎn)超廣譜β-內(nèi)酰胺酶腸桿菌顯色培養(yǎng)基(圖5.5)等。
注:紅色——B族鏈球菌;藍(lán)色——腸球菌

2、CHROMagar(科瑪嘉) 科瑪嘉微生物在1993年由Alain Rambach 成立,他也是科瑪嘉顯色培養(yǎng)基的開拓者。目前,科瑪嘉提供的培養(yǎng)基覆蓋臨床細(xì)菌學(xué)、工業(yè)微生物學(xué)、食品和飲料行業(yè)的食源性致病菌,包括沙門菌、金黃色葡萄球菌、白色念珠菌、大腸桿菌O157、B族鏈球菌、大腸桿菌、李斯特菌、弧菌和假單胞菌?片敿问秋@色培養(yǎng)基技術(shù)創(chuàng)新領(lǐng)域的領(lǐng)導(dǎo)者,通過其高效的全球經(jīng)銷網(wǎng)絡(luò)提高國(guó)際影響力。2013年3月3日科瑪嘉發(fā)布了篩查無乳鏈球菌的培養(yǎng)基,見圖5.6。該培養(yǎng)基比格拉納達(dá)及CAN更好的靈敏度,在無氧條件下培養(yǎng)24h,用肉眼可觀察到一種顏色強(qiáng)烈的紫紅色溶血性和非溶血性鏈球菌,則為無乳鏈球菌。
3、法國(guó)生物梅里埃 生物梅里埃公司是一家專業(yè)研究、生產(chǎn)微生物檢測(cè)產(chǎn)品和自動(dòng)化微生物檢驗(yàn)儀器的全球性的法國(guó)公司。1979成功申請(qǐng)第一個(gè)顯色培養(yǎng)基的專利,Rambach瓊脂培養(yǎng)基早在1989年上市,在市面上銷售。接著就有其他培養(yǎng)基的陸續(xù)推出,其中包括各種普通培養(yǎng)基(干粉、成品、平板)、顯色培養(yǎng)基、Count-Tact環(huán)境檢測(cè)平板、API試劑條、VIDAS全自動(dòng)致病菌分析儀、ATB自動(dòng)微生物鑒定系統(tǒng)、Leader 50i基因探針化學(xué)發(fā)光檢測(cè)儀、NUCLISENS READER核酸擴(kuò)增自動(dòng)檢測(cè)儀、Air IDEAL空氣微生物采樣器、產(chǎn)氣袋及厭氧培養(yǎng)系統(tǒng)、膠乳凝集產(chǎn)品、DENKA SEIKEN診斷血清等。產(chǎn)品覆蓋了從細(xì)菌增菌、快速篩檢、分離增養(yǎng)、染色鏡檢、生化鑒定及血清鑒定的全過程,其中顯色培養(yǎng)基是該公司主要的產(chǎn)品之一。
4、環(huán)凱微生物 廣東環(huán)凱微生物科技有限公司是廣東省微生物研究所(隸屬于中國(guó)科學(xué)院廣州分院和廣東省科學(xué)院)屬下的國(guó)家級(jí)高新技術(shù)企業(yè)。1993年成立,致力于生物安全檢測(cè)與控制產(chǎn)品的研發(fā)、生產(chǎn)和經(jīng)營(yíng),是國(guó)內(nèi)最大的微生物和微生物控制產(chǎn)品生產(chǎn)企業(yè)之一。其中微生物檢測(cè)產(chǎn)品是其主要的產(chǎn)品,種類繁多,如顯色培養(yǎng)基、微生物干燥培養(yǎng)基、新型微生物生化鑒定系統(tǒng)和一次性成品培養(yǎng)基等等。環(huán)凱新推出的顯色培養(yǎng)基有大腸菌群顯色培養(yǎng)基,見圖5.7-1;單增李斯特顯色培養(yǎng)基,見圖5.7-2。
5、海博生物 青島高科技工業(yè)園海博生物技術(shù)有限公司2000年2月1日成立,主要專注于微生物培養(yǎng)基的研發(fā)和生產(chǎn),產(chǎn)品包括微生物干粉培養(yǎng)基、顆粒培養(yǎng)基、顯色培養(yǎng)基、即用型培養(yǎng)基等各種培養(yǎng)基,是國(guó)內(nèi)微生物產(chǎn)品品種最多的廠家之一。 其生產(chǎn)銷售的顯色培養(yǎng)基包含有念球菌、阪崎桿菌、大腸桿菌、沙門菌、金黃色葡萄球菌、李斯特菌顯色培養(yǎng)基。
6、康泰生物 溫州市康泰生物科技有限公司成立于2000年,是專業(yè)從事于微生物體外診斷試劑與儀器研發(fā)、生產(chǎn)、銷售的“浙江省科技創(chuàng)新型企業(yè)”。現(xiàn)有產(chǎn)品注冊(cè)證150多個(gè),產(chǎn)品主要包括微生物藥敏試劑、藥敏試紙、乳膠凝集快速診斷試劑、金標(biāo)痕量快速診斷試劑、培養(yǎng)基、染色液、質(zhì)控菌株、免疫印跡產(chǎn)品等幾大系列。其中各種規(guī)格、方法的微生物藥敏檢測(cè)系列產(chǎn)品有200余種,是其主要產(chǎn)品。其新近推出的念珠菌顯色培養(yǎng)基,見圖5.8。
三、B族鏈球菌顯色培養(yǎng)基
1、概述 B族鏈球菌(Group B Streptococcus,GBS)又名無乳鏈球菌,屬于革蘭陽(yáng)性菌。正常寄居于陰道和直腸,它是一種條件致病菌,圍產(chǎn)期婦女在分娩過程中,新生兒在通過產(chǎn)道時(shí)可被感染。其主要危害群體是孕產(chǎn)婦和新生兒。GBS檢測(cè)在歐美國(guó)家(美國(guó)、法國(guó)、意大利)多為必檢項(xiàng)目,近三年我國(guó)對(duì)該項(xiàng)檢測(cè)開始日益受重視。GBS現(xiàn)有的檢測(cè)方法:
(1)細(xì)菌鑒定儀法:準(zhǔn)確度高,費(fèi)用較高,不能直接上標(biāo)本,純菌培養(yǎng)時(shí)間長(zhǎng);
(2)普通培養(yǎng)加生化鑒定法:該法為GBS檢測(cè)的 “金標(biāo)準(zhǔn)”,其特異性好,但是需要細(xì)菌純培養(yǎng),鑒定試驗(yàn)繁瑣;
(3)分子生物學(xué)方法(PCR法):該法檢測(cè)快速、敏感,但是假陽(yáng)性較難排除,對(duì)人員和設(shè)備要求較高;
(4)免疫學(xué)方法(層析法):該法特異性好,但靈敏度較低;
(5)乳膠凝集法:其特異性好,但細(xì)菌純化培養(yǎng)時(shí)間長(zhǎng);
(6)顯色培養(yǎng)法:它的靈敏度高、特異性好,可直接上標(biāo)本,使用方法和傳統(tǒng)培養(yǎng)方法相同,無特殊要求,簡(jiǎn)便易行。
2、GBS顯色培養(yǎng)基的生產(chǎn)產(chǎn)家 目前國(guó)內(nèi)涉及GBS顯色培養(yǎng)基的生產(chǎn)廠家有:廣州瑞輝生物醫(yī)療科技有限公司(2012年正式成立,2015年完成股改,董事長(zhǎng)李有生)、珠海迪爾生物工程有限公司、梅里埃(上海)生物制品有限公司、鄭州安圖生物工程股份有限公司。B族鏈球菌顯色平板(見圖5.9)的特點(diǎn)是顯色明顯,易于區(qū)分,結(jié)果判斷簡(jiǎn)便;選擇、分離、培養(yǎng)、鑒定同時(shí)進(jìn)行,一步到位檢測(cè)B群鏈球菌,快捷;與平板檢測(cè)限相同,靈敏度高;其他細(xì)菌、真菌不干擾GBS顯色,特異性好;適用于任何標(biāo)本的GBS檢測(cè),尤其適用于圍產(chǎn)期GBS篩查。
我國(guó)除了少數(shù)生產(chǎn)廠家的B族鏈球菌顯色培養(yǎng)基外,該培養(yǎng)基主要還是依靠進(jìn)口,比較有名要數(shù)法國(guó)科瑪嘉,基本上壟斷了整個(gè)顯色培養(yǎng)基的市場(chǎng)。然而2016年珠海銀科醫(yī)學(xué)工程股份有限公司引入了Biolife Italiana公司的顯色培養(yǎng)基,它的顯色培養(yǎng)基的效果跟法國(guó)科瑪嘉的產(chǎn)品結(jié)果不相上下。
四、小結(jié)
顯色干粉培養(yǎng)基是近年來發(fā)展起來的一種新型培養(yǎng)基,它是將現(xiàn)代化學(xué)合成技術(shù)、細(xì)菌代謝組學(xué)與目前尚不可替代的傳統(tǒng)方法相結(jié)合應(yīng)用于細(xì)菌檢驗(yàn)領(lǐng)域的一項(xiàng)新技術(shù)。與傳統(tǒng)培養(yǎng)基相比,顯色培養(yǎng)基克服了傳統(tǒng)培養(yǎng)基在各種細(xì)菌分離、鑒別、計(jì)數(shù)等操作過程中比較復(fù)雜(需要有經(jīng)驗(yàn)的技術(shù)人員)、敏感性低和特異性差的缺點(diǎn)。顯色培養(yǎng)基在檢測(cè)細(xì)菌時(shí),通過觀察菌落顏色即能用肉眼對(duì)細(xì)菌進(jìn)行定性或定量分析,既縮短了檢測(cè)時(shí)間,又免除了后續(xù)生化鑒定的過程,極大提高了工作效率。
郵政編碼:200052 電話:021-63800152 傳真:021-63800151 京ICP備15010734號(hào)-10 技術(shù):網(wǎng)至普網(wǎng)站建設(shè)